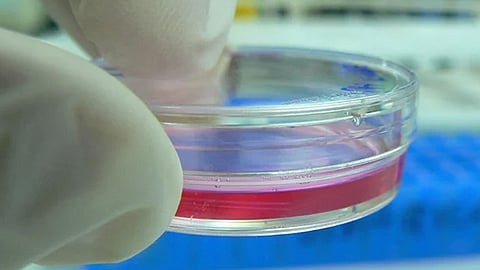

الخلايا الجذعية
تمكن باحثون من معهد ملبورن الملكي للتكنولوجيا (RMIT) من استخدام الموجات الصوتية لتحويل الخلايا الجذعية إلى خلايا عظمية.
وبحسب «روسيا اليوم»، فإن تطوير هذه التقنية يعد تقدما في هندسة الأنسجة الذي يمكن أن يساعد المرضى يومًا ما على إعادة نمو العظام المفقودة بسبب السرطان أو الأمراض التنكسية.
ويعد تطوير هذه التقنية تقدمًا في هندسة الأنسجة الذي يمكن أن يساعد المرضى يومًا ما على إعادة نمو العظام المفقودة بسبب السرطان أو الأمراض التنكسية.
وتتميز الخلايا الجذعية بالقوة الخارقة للتحول إلى أي نوع آخر من الخلايا، وهي قدرات تستخدمها بعض الحيوانات لإعادة نمو الأطراف، وفي ما يتعلق بالطب، فإنها توفر إمكانية مساعدتنا في إصلاح أجزاء من جسم الإنسان التي تضررت بسبب الإصابة أو المرض.
ويحتاج إجراء هذه الإصلاحات القدرة على معالجة الخلايا الجذعية عند الطلب، وتوضح الدراسة الجديدة طريقة مبتكرة للقيام بذلك، والمتمثلة في استخدام موجات صوتية عالية التردد لتحويل الخلايا الجذعية إلى خلايا عظمية في أقل من خمسة أيام، مع 10 دقائق من العلاج التحفيزي في اليوم.
وفي هذا الصدد، تقول آمي جيلمي، نائب المستشار في معهد ملبورن الملكي للتكنولوجيا (RMIT) في أستراليا: "تقلل الموجات الصوتية من وقت العلاج المطلوب عادة لجعل الخلايا الجذعية تبدأ في التحول إلى خلايا عظمية لعدة أيام. ولا تتطلب هذه الطريقة أيضًا أي عقاقير خاصة تحفز العظام، ومن السهل جدًا تطبيقها على الخلايا الجذعية".
وجاءت التقنية الجديدة بعد سنوات من العمل على تعديل المواد بموجات صوتية أعلى من ترددات تبلغ 10 ميغاهرتز، وهي ترددات أعلى بكثير مما استخدمه الباحثون سابقًا في هذه الأنواع من التجارب.
ووقع استخدام شريحة ميكروية لتحويل الخلايا الجذعية الموضوعة في زيت السيليكون ووضعها على صفيحة زرع.
وسجلت العمليات التجريبية الأخرى في هذا المجال بعض النجاح، لكنها أيضًا معقدة الإعداد ومكلفة للإدارة، ويصعب توسيعها. كما أنها تتطلب خلايا جذعية مستخرجة من نخاع عظم المريض، وهو إجراء مؤلم. وهذا النهج الجديد هو تحسن في كل تلك المجالات.